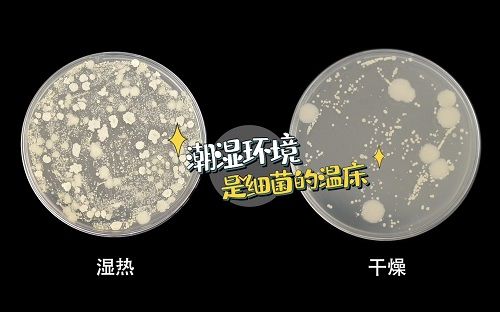

科普试验告诉你,火鸡消毒刀架为什么在顶端
刷微信运动步数、严格控制卡路里、精心搭配每日饮食……人们追求健康的花样越来越多。不过除了自我提升以外,还有很多影响健康的外在因素。小编和几个朋友都是健康达人,前几天我们一起聊天时发现,原来厨房里的刀架也有学问。
刀架不一定每家都有,但大家应该都不陌生,买整套刀具时常常会赠送一个木质的。对于这个看似可有可无的厨具,网友们总结出一套鄙视链,小编给大家整理了一下,希望大家在追求健康生活时能重视这个厨房卫生小死角。
随手放<木质刀架<智能刀架
鄙视链最底端的是将刀具随手放,这种方法似乎不能被称为收纳。有时放在抹布上,有时靠在满是油烟的墙壁上,有时还和菜板组cp。这些都是细菌非常喜欢居住的区域,一旦病菌污染到餐具和刀具,就容易通过食物进入人体引发疾病,小编觉得只要有一些健康意识就不应该这么随意地对待。

比随手放高阶一点的是木质刀架,不仅美观、具备收纳功能,还不会与厨房里各种污染表面直接接触。小编家里之前用的就是木质刀架,是买了好几把刀赠送的,当时觉得自己捡了便宜,结果被鄙视链缠住了。
这个木质刀架我用了很久,刚开始觉得很方便,后来长期摆在又热又潮湿的厨房,它的外表都发黑了。我甚至怀疑内部也是黑点斑斑,发霉严重,在梅雨天竟然还有小虫从里面爬出,但苦于不能拆洗。对于追求健康生活的我来说,肯定是零容忍。

那么在刀架界俯视“芸芸众生”的是什么呢?是将紫外线消毒和烘干功能完美结合的智能刀架。大家可能听说过智能马桶、AI音箱,是不是想象不到刀架也有智能的?为什么它能跳出鄙视链C位出道,其实都是有学问的。
刀具卫生怎么破:pick紫外线+干燥
大家可能不太理解鄙视链的原理,小编分享出一个科普视频,让我们一起仔细盘一盘。
视频内容是火鸡电器联合浙江工商大学现代食品安全与营养协同中心进行的实验,测试了日常刀、餐具清洗消毒方法和放置环境,来和小编一起看看吧。
可以看到,水煮和紫外线照射的灭菌效果,明显比洗洁精清洗好得多,平常只用清水冲洗的小编真的抬不起头。但是100℃沸水中煮10分钟的条件对家庭来说很难达到,而且容易造成烫伤。因此从难易度和清洁度来看,大家应该尝试一下紫外线消毒。

我们再来看看放置环境的对比,视频中说高温潮湿组的菌落家族很兴盛,形态显著大于室温干燥环境。所以,清洁干净的刀、餐具若是没有良好的放置环境,还会遭到二次污染。不只是小编,相信很多人都还没有意识这一点,天真地认为厨房卫生只要对餐具的彻底清洗即可,却不知道病菌一直在各个角落暗中观察。
说到病菌,家庭厨房的常客有黄曲霉菌、大肠杆菌、幽门螺杆菌,它们都是健康的“隐形杀手”。
黄曲霉菌曾被世界卫生组织的癌症研究机构划定为1类致癌物,是一种毒性极强的剧毒物质,会对人类肝脏组织造成破坏,严重时会导致肝癌甚至死亡。
大肠杆菌主要通过食物和水进行传播,会引起呕吐、腹泻等症状。
另外,口臭的朋友们要注意了,很有可能是因为幽门螺杆菌在作祟,这个家伙有时还会引起慢性胃炎,喜欢通过刀具、餐具和水寻找下一个对象。

(幽门螺杆菌)
这样来看,厨房处处潜伏着健康隐患,就连直接与食物接触的刀具也得防范。所以,一定得用上实验告诉我们的小窍门——紫外线消毒+保持干燥。不过,对于小小的家庭厨房来说,满足这两点仍然不容易。
但是,大家还记得鄙视链C位出道的智能刀架吗?小编前几天入手了一款名叫“火鸡”的消毒刀架,它就将紫外线和干燥环境完美结合,275nm波长紫外线无死角照射,发热模块和风扇,每4小时烘干一次,能强力杀死99%的细菌。幽门螺旋杆菌、大肠杆菌、黄曲霉菌等等都不是它的对手。另外,火鸡采用的材质抗菌防霉,还方便拆洗,这一点就完爆传统木质刀架,梅雨天也不用担心。
颜值上,火鸡深深击中了外貌协会的我,科技感十足。同时,它还能放进十几把刀,而木质刀架固定了样式,之前小编家的最多只能放6把,对于刀的大小也有限制,不得不说有点呆板。

现在马上进入盛夏,对于小编来说,厨房更加一秒都不想多呆,每次打扫厨房都会满头大汗,但又不敢松懈。这款刀架真的解放了我,省时又省心。以后如果种草了其他好物小编也会分享出来,希望大家对待健康不将就。
此文内容为企业宣传资讯,仅代表作者个人观点,与本网无关。仅供读者参考,并请自行核实相关内容。如果您发现网站上有侵犯您的知识产权的作品,请与我们取得联系,邮箱: zixunrexian@126.com ,我们会及时修改或删除。
网址:科普试验告诉你,火鸡消毒刀架为什么在顶端 https://c.jiaju82.com/news-view-id-706647.html

